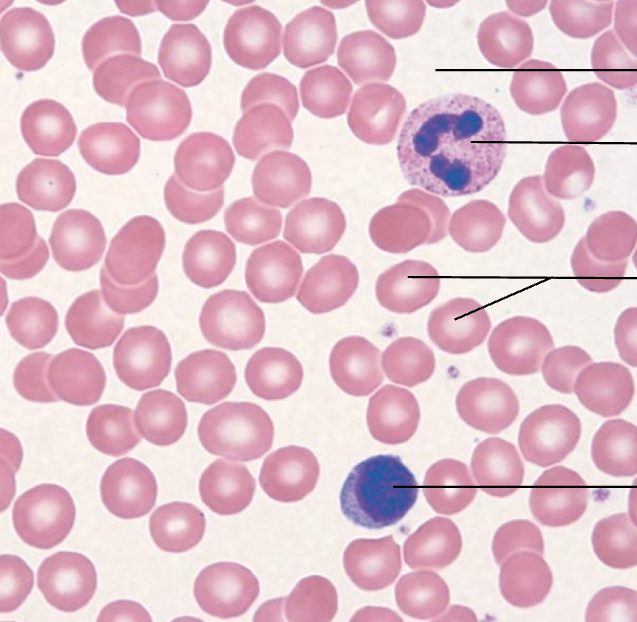

function: allows materials to pass by diffusion and filtration where protection is not important & secretes lubricating substances in serosae
location: air sacs of lungs and lining of ventral body cavity
simple squamous epithelium

function: secretion & absorption
location: kidney tubules and ovary surface
simple cuboidal epithelium

function: absorption & secretion of mucus
location: nonciliated lines most of digestive tract & ciliated lines uterus
simple columnar epithelium

function: secretes substances & propulsion of mucus by ciliary action
location: lines trachea & upper respiratory tract
pseudostratified columnar epithelium

function: protects underlying tissues in areas subjected to abrasion
location: nonkeratinized forms linings in mouth & vagina
stratified squamous epithelium

function: protection
location: largest ducts of sweat glands & mammary glands
stratified cuboidal epithelium

function: protection & secretion
location: small amounts in male urethra & large ducts of some glands
stratified columnar epithelium

function: stretches readily & permits distention of urinary organ by contained urine
location: lines the ureters & bladder
transitional epithelium

function: gives rise to all other connective tissue types
location: embryo
embryonic connective tissue: mesenchyme

function: wraps and cushions organs & holds tissue fluid
location: under epithelia of body & packages organs
connective tissue proper: loose connective tissue, areolar

function: provides reserve fuel & insulates against heat loss
location: under skin & in breasts
connective tissue proper: loose connective tissue, adipose

function: fibers form a soft internal skeleton (stroma) that support other cell types including white blood cells, mast cells, and macrophages
location: lymphoid organs (lymph nodes, bone marrow, and spleen)
connective tissue proper: loose connective tissue, reticular

function: attaches muscles to bones & attaches bones to bones
location: tendons, ligaments, aponeuroses
connective tissue proper: dense connective tissue, dense regular

function: able to withstand tension in many directions & provide structural strength
location: fibrous capsules of organs and joints & dermis of skin
connective tissue proper: dense connective tissue, dense irregular

function: allows recoil of tissue following stretching & maintains pulsatile flow of blood through arteries
location: walls of large arteries & walls of bronchial tubes
connective tissue proper: dense connective tissue, elastic

function: supports and reinforces & resilient cushion
location: cartilage of nose and trachea
cartilage: hyaline

function: maintains the shape of a structure while allowing flexibility
location: external ear (auricle) & epiglottis
cartilage: elastic

function: tensile strength with the ability to absorb compressive shock
location: intervertebral discs & pubic symphysis & discs of knee joint
cartilage: fibrocartilage

function: supports and protects (by enclosing) & provides levers for the muscles to act on
location: bones
connective tissue: bones

function: transport respiratory gases, nutrients, and wastes
location: within blood vessels
connective tissue: blood
function: voluntary movement & locomotion
location: in skeletal muscles attached to bones or occasionally to skin
muscle: skeletal

function: propels blood into circulation & involuntary control
location: walls of the heart
muscle: cardiac

function: propels substances or objects along internal passageways & involuntary control
location: in the walls of hollow organs
muscle: smooth

function: neurons transmit electrical signals from sensory receptors and to effectors (muscles and glands) & supporting cells support and protect neurons
location: brain, spinal cord, nerves
nervous tissue



